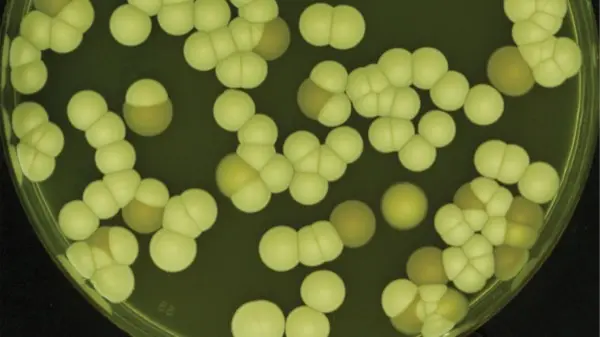

Candida auris isolates collected in Michigan hospitals showed greater susceptibility to amphotericin B but reduced susceptibility to several azoles compared with isolates from other regions, while all remained highly susceptible to echinocandins, including the next-generation agent rezafungin (Rezzayo, Melinta), according to a new laboratory study from Henry Ford Health System.
C. auris continues to emerge as a major healthcare-associated threat because of its ability to persist in the environment and spread within hospitals and long-term care facilities. In 2023, the CDC reported that U.S. cases had tripled between 2020 and 2021, with a threefold increase in cases that were resistant to echinocandins. Multiple clades have been identified with different geographic penetrance.
Better Performance With Echinocandins
The analysis, presented by Katherine Klamer, MS, of Henry Ford’s Clinical Scholar Laboratory, at IDWeek 2025, in Atlanta (abstract P-1942), evaluated 67 C. auris isolates (39 from Michigan, 28 from other U.S. sites). Ten antifungal agents were tested—amphotericin B, anidulafungin, caspofungin, micafungin, rezafungin, fluconazole, isavuconazole, itraconazole, posaconazole, and voriconazole—using broth microdilution susceptibility testing (Sensititre YeastOne).
All C. auris isolates tested were 100% susceptible to the echinocandin class—including rezafungin—with minimum inhibitory concentrations (MICs) of 0.06 mcg/mL or lower. Amphotericin B susceptibility was 98.5% among Michigan isolates and 81.8% for those from other regions. Azole activity was low overall, with fluconazole susceptibility around 10% in Michigan isolates and 25% in other samples. MICs for other azoles followed the same trend, suggesting higher resistance in Michigan strains.
Fighting C. auris With Surveillance
“The findings underscore the importance of regional antifungal surveillance,” Klamer stated, noting that differences in clade distribution and resistance patterns may influence local treatment options. “Regional susceptibility testing of C. auris should be considered because of variability among clades and the therapeutic options clinicians need when treating serious C. auris infections.”
“It’s a difficult organism to eradicate once it’s in a facility,” said Taylor Morrisette, PharmD, an assistant professor of pharmacy at the Medical University of South Carolina, in Charleston, in an interview with Infectious Disease Special Edition. “It can go to all different parts of the body, including blood, skin, and bone, and it spreads very easily in the hospital.” The pathogen’s rapid global spread and the detection of distinct genetic clades in different U.S. regions make ongoing surveillance essential, he added.
A Job for Rezafungin
Rezafungin, approved in 2023 as the first once-weekly echinocandin, is drawing attention for its long half-life and optimized pharmacokinetics. “Traditional echinocandins are given daily, and many of the other antifungals have issues like drug interactions, QTc prolongation, or nephrotoxicity,” Dr. Morrisette said.
He noted that rezafungin’s potent in-vitro activity aligns well with the Henry Ford findings. “The echinocandins remain the treatment of choice for C. auris because it’s still an emerging pathogen, and we see variable resistance with the other classes,” he said, noting that the observed geographic variability reinforces the need for local antifungal susceptibility data. “Rates of resistance could be 10% in one area of the country and 90% in another. You always want to know your local susceptibility rates for a given drug against a particular pathogen.”
The sources reported no relevant financial disclosures. Dr. Morrisette is a member of the IDSE editorial advisory board.
This article is from the February 2026 print issue.